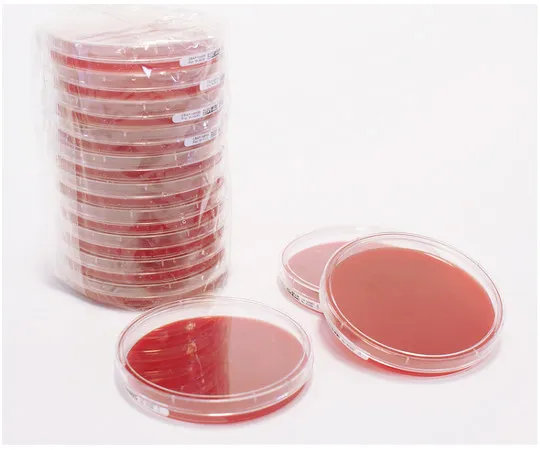

Analyzer, Testing Equipment
61-0190-74 Columbia Blood Agar Pharm. (20) 146559 20PACK 1.46559.0020
Product Description
Product Model: 61-0190-74Product Brand: Merck Millipore […]
Contact Us
Product Details
Product Model: 61-0190-74
Product Brand: Merck Millipore Corporation
Spec
- ※We ask for your kind understanding that lead time might change If it is out of stock in Japan.
Related product recommendations
You may also be interested in the following products
61-0376-74 [Discontinued]3-Bromopropionitrile for Synthesis 841334 25mL 8.41334.0025
model: 61-0376-74
brand: Merck Millipore Corporation
61-0321-66 Chromium ICP Standard Solution Traceable For SRM Of NIST[cr (NO3) 3 in HNO3 2-3%], 1000mg/L Cr Certipur(R) 170312 100mL 1.70312.0100
model: 61-0321-66
brand: Merck Millipore Corporation
61-6948-40 Light Path Corrector 266nm WSQNA-50S03-1-266-0/45D
model: 61-6948-40
brand: SIGMAKOKI CO., LTD.
61-0405-06 [Discontinued]Fmoc-D-Gln(Trt)-Wang Resin 856156 5G 8561560005
model: 61-0405-06
brand: Merck Millipore Corporation